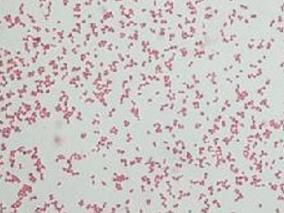
头孢唑林vs广谱头孢菌素用于成人菌血症经验性治疗的疗效

-
院前NSAIDs使用延长胸膜-肺感染患者住院时间
环球医学资讯
2017年02月27日
点击量:285
1小时条评论院前非甾体抗炎药(NSAID)的使用可能影响肺炎进程。2017年2月,发表在《Respir Med.》的一项研究评价了院前使用NSAIDs对胸膜-肺感染患者住院时间的潜在影响。 研究人员开展一项前瞻性观察性研究,纳入57例确诊...
-
幽门螺杆菌感染的治疗:ACG临床指南
环球医学资讯
2017年02月16日
点击量:539
1小时条评论幽门螺杆菌病是一种螺旋形、微厌氧、对生长条件要求十分苛刻的细菌。1983年首次从慢性活动性胃炎患者的胃黏膜活检组织中分离成功,是目前所知能够在人胃中生存的惟一微生物种类。2017年2月,发表在《Am J Gastroe...
-
ICU患者输注血小板与医院获得性感染相关?
环球医学资讯
2017年02月14日
点击量:482
1小时条评论血小板减少在危重症患者中很常见,是ICU内常见的并发症。2017年1月,发表在《Crit Care》的一项由澳大利亚和法国科学家进行的研究考察了ICU患者输注血小板与医院获得性感染的相关性。 背景:危重症患者常常需要...
-
HIV阳性患者他汀一级预防是否安全有效?
环球医学资讯
2017年02月04日
点击量:532
1小时条评论2016年12月,发表在《Eur Heart J》的一项由意大利和美国科学家进行的系统评价和荟萃分析,考察了人类免疫缺陷病毒阳性患者他汀一级预防的相对安全性和有效性。 不同他汀一级预防对人类免疫缺陷病毒(HIV)阳性...
-
革兰氏阴性血流感染:经验性抗菌治疗不当会延长住院…
环球医学资讯
2017年01月20日
点击量:425
1小时条评论2017年1月,发表在《J Antimicrob Chemother》的一项在美国开展的回顾性队列研究考察了革兰氏阴性血流感染中,经验性抗菌治疗不当和住院日之间的关系。 目的:初始表现为革兰氏阴性血流感染(BSI)的预后良好的...
-
中国COBSI中ESBL-EC和ESBL-KP的流行病学和风险因素
环球医学资讯
2017年01月19日
点击量:594
1小时条评论产ESBL大肠杆菌(ESBL-EC)和产ESBL肺炎克雷伯菌(ESBL-KP)造成的社区发生的血液感染(COBSIs)在全球范围内增加。2017年1月,发表在《J Antimicrob Chemother》的一项研究旨在调查中国COBSI中ESBL-EC和ESBL-KP...
-
成人念珠菌病:棘白菌素vs氟康唑
环球医学资讯
2017年01月19日
点击量:360
1小时条评论近平滑假丝酵母念珠菌可引起泌尿生殖道感染、肺的深部感染,也可致败血症。常见发病诱因有妊娠、糖尿病、大量应用免疫抑制剂及广谱抗生素。2016年12月,发表在《J Antimicrob Chemother》的研究对棘白菌素vs氟康...
-
败血症和机械通气的ICU患者中米卡芬净变异性分析
环球医学资讯
2017年01月19日
点击量:256
1小时条评论米卡芬净是通过对Coleophoma empetri的天然产物进行改造,化学合成得到的新型棘白菌素类抗真菌药物。它对念珠菌有较好的抑制活性。2016年8月,发表在《J Antimicrob Chemother》的研究对败血症和机械通气的ICU患...
-
HIV感染者初次急性冠脉综合征后血脂水平控制较差
环球医学资讯
2017年01月19日
点击量:428
1小时条评论对于HIV感染患者血脂管理二级预防的认知有限。2017年1月,发表在《Am Heart J.》上的一项研究显示,同对照者相比,HIV感染者初次急性冠脉综合征后血脂水平控制较差,尤其是最初6个月且接受的他汀较少。 背景:对...
-
头孢唑林vs广谱头孢菌素用于成人菌血症经验性治疗的…
环球医学资讯
2017年01月17日
点击量:736
1小时条评论2016年12月,发表在《International Journal of Antimicrobial Agents》的一项倾向性评分匹配分析,比较了头孢唑林和广谱头孢菌素用于成人社区获得性大肠埃希菌、肺炎克雷伯菌、奇异变形杆菌菌血症经验性治疗的疗...

会员登录


网友评论
Yvette05-22
脱发一直是很多人的困扰,希望能广泛应用。
Ada305-22
补碘知识非常全面,获益匪浅。
penelope05-22
“盐重”问题确实需要重视